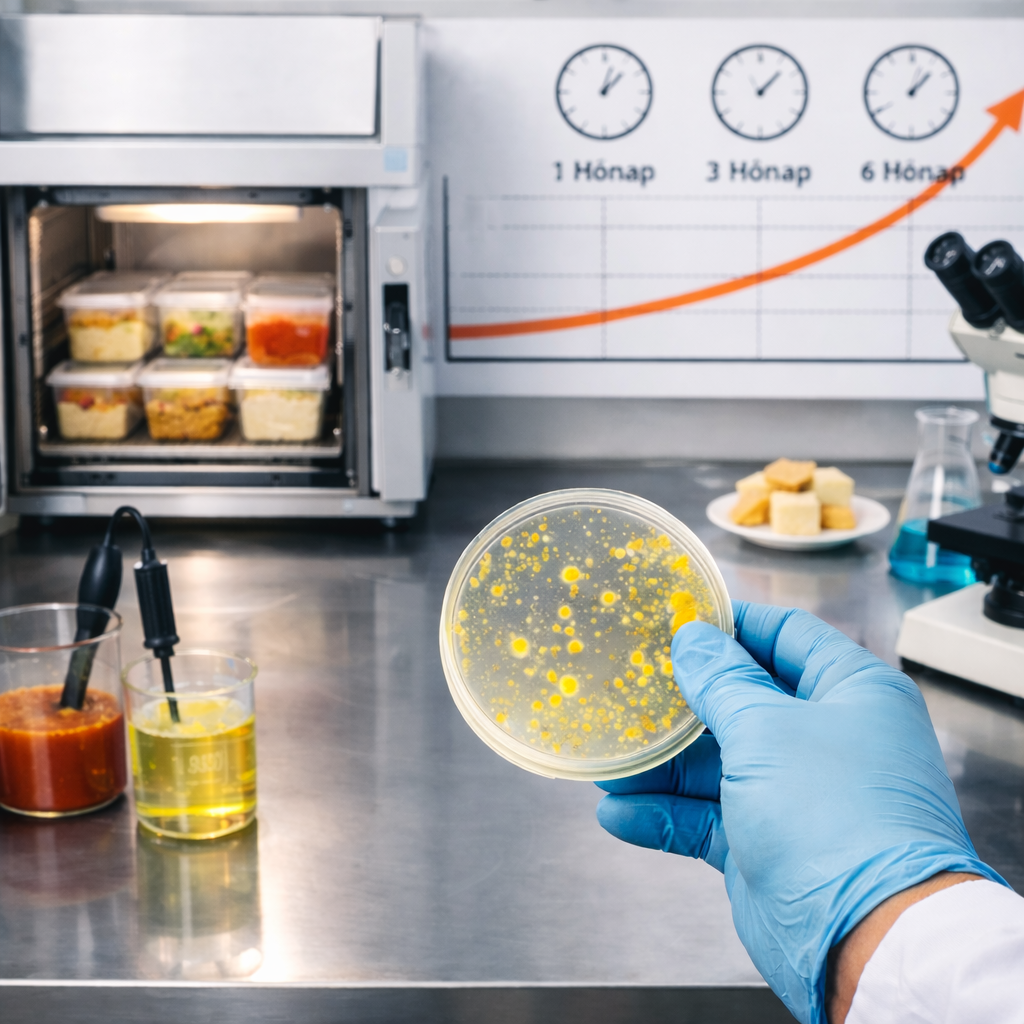

A szakmai tudástól a nyilvánosságig
A budapesti ivóvíz ólomszennyezéséről szóló Qubit-anyag és a devizahiteles perek körüli országos jogi vita új szintre emelte a Szunyogh Content Studio munkáját. A negyedik esettanulmányunk bemutatja, hogyan lesz a szakmai tudásból tartalom, a tartalomból médiamegjelenés, a médiamegjelenésekből pedig tartós szakmai láthatóság.